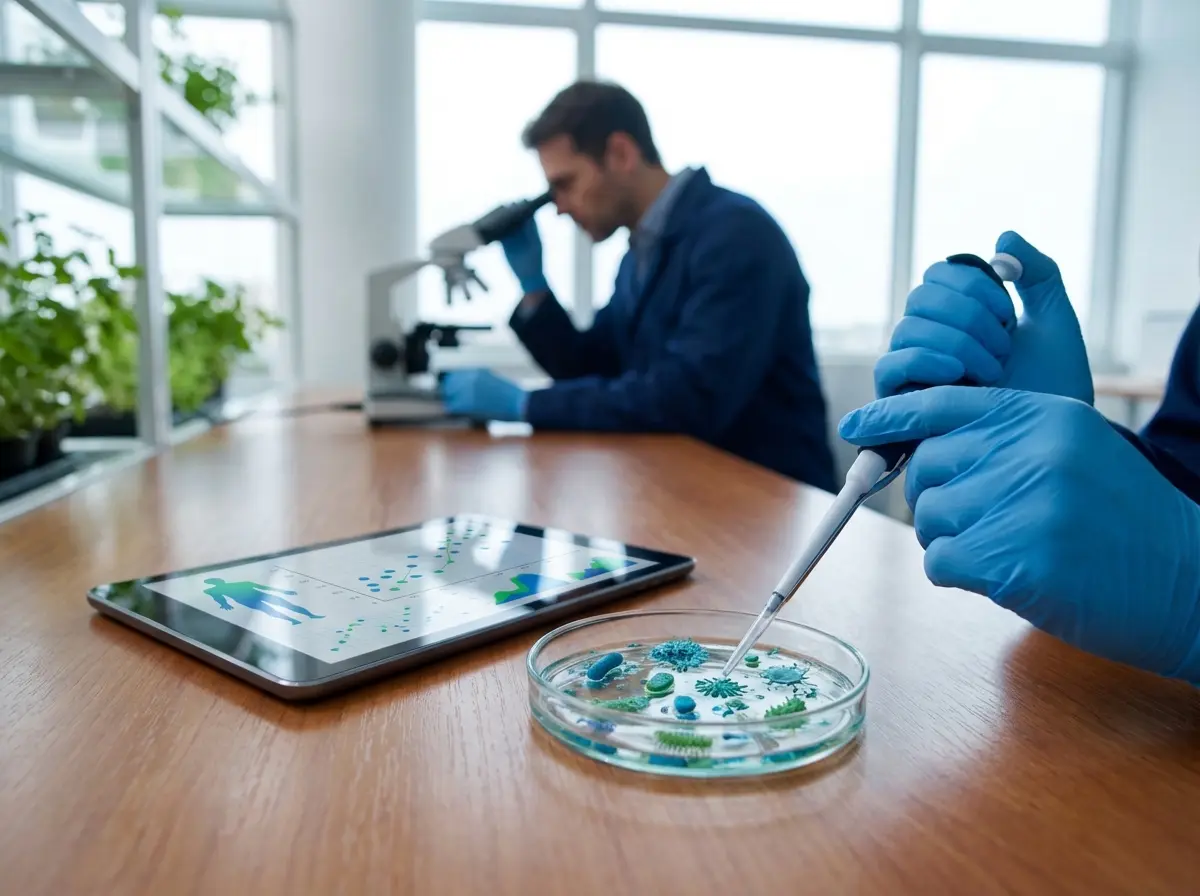
The Science Behind Non Surgical Weight Loss and Clinical Metabolic Health

Are you exhausted by the endless cycle of restrictive dieting and minimal physical results? Non surgical weight loss programs offer a highly powerful medical weight loss alternative for individuals seeking significant results without undergoing invasive surgical operations. This comprehensive clinical approach combines advanced medical therapies, behavioral science, and metabolic optimization to help you reach your specific health goals. By focusing on the root causes of weight gain, these programs provide a sustainable path toward improved vitality and long-term wellness.
Obesity is now widely recognized by the American medical community as a complex, chronic metabolic disease requiring specialized obesity treatment and long-term clinical management. Your body actively resists significant fat reduction through an evolutionary process called metabolic adaptation, which often complicates traditional weight loss efforts. When you reduce your caloric intake significantly, your resting metabolic rate automatically slows down to preserve energy stores and prevent starvation.
This biological survival mechanism makes traditional calorie counting incredibly frustrating for most patients over the long term without professional medical intervention. Medical researchers have discovered that successfully treating obesity requires addressing these underlying metabolic pathways directly and consistently through targeted clinical protocols. Non surgical weight loss protocols target the specific physiological hormones that regulate your appetite, satiety signals, and long-term fat storage.
By utilizing modern medical therapies, you can effectively override these ancient survival signals that block fat reduction and hinder your progress. This scientifically backed approach allows your body to release stored fat while maintaining crucial lean muscle mass for a healthier composition. You achieve sustainable results because you are finally working in harmony with your biology rather than fighting against your natural instincts.
Furthermore, chronic inflammation often accompanies excess adipose tissue, creating a destructive feedback loop inside your body that prevents efficient weight loss. This systemic inflammation actively impairs your cellular insulin sensitivity, making further fat reduction increasingly difficult for the average individual to achieve. Medical weight management protocols directly reduce this inflammation, restoring your normal metabolic function and improving your overall health profile over time.
- Metabolic adaptation causes your body to resist traditional calorie restriction naturally.
- Modern medical protocols target specific hormones to override biological survival signals.
- Reducing systemic inflammation is necessary for restoring proper metabolic function.
Effective Medical Weight Loss and Non Surgical Weight Loss Interventions Without the Scalpel

Patients today have access to highly effective medical weight loss treatments that require absolutely zero recovery time or surgical intervention. These clinical interventions bridge the massive gap between basic lifestyle modifications and invasive surgical operations for those needing significant help. Physicians carefully evaluate your personal health history to determine which specific medical tools will yield the best long-term outcomes for you.
Advanced Medical Weight Loss: Prescription Weight Management Medications and GLP-1s
The FDA has recently approved a new class of highly effective medications called GLP-1 receptor agonists for non-invasive weight loss. Drugs like semaglutide and tirzepatide mimic natural hormones that tell your brain you are completely full and satisfied after eating. Clinical trials demonstrate that patients using these targeted medications can lose up to twenty percent of their total body weight safely.
These pharmaceutical options represent a massive breakthrough for individuals managing severe, chronic metabolic resistance and difficult weight management challenges. The medications also slow down gastric emptying, which keeps you physically satisfied for much longer periods after consuming your meals. Doctors typically prescribe these advanced treatments as part of a broader, comprehensive bariatric surgery alternatives program for maximum efficacy.
Non-Invasive Endoscopic Procedures for Non Surgical Weight Loss
For those who prefer to avoid long-term medication, endoscopic procedures offer another highly effective non-invasive weight loss alternative for patients. Gastroenterologists can place an intragastric balloon into your stomach through your mouth while you are lightly sedated for the procedure. This temporary medical device occupies physical space in your stomach to restrict your portion sizes naturally and safely without surgery.
Another popular outpatient option is Endoscopic Sleeve Gastroplasty (ESG), which reduces stomach volume without making any exterior incisions or permanent changes. The physician uses an endoscope to place internal sutures, significantly limiting how much food your stomach holds during each meal. These advanced procedures provide surgical-level restriction while allowing patients to return home the exact same day to begin recovery.
Always verify that your chosen clinical provider prescribes FDA-approved medications rather than unregulated compounded alternatives for your safety. This guarantees you receive the exact molecular formulation tested in clinical trials for safety and efficacy during your journey.
Building a Sustainable Nutritional Foundation for Long-Term Weight Management
Medical interventions provide a powerful catalyst, but proper nutrition remains absolutely essential for maintaining your fat reduction results long-term. You must prioritize high-quality protein intake to preserve lean muscle tissue while your body sheds excess fat during the program. A registered dietitian can help you structure meals that stabilize your blood sugar throughout the entire day for better energy.
Many restrictive diets fail miserably because they eliminate entire food groups and create overwhelming psychological deprivation for the average person. A sustainable nutritional approach focuses heavily on adding nutrient-dense whole foods rather than strictly punishing your daily choices or habits. This balanced strategy helps you develop a much healthier relationship with food over the long term for lasting success.
Hydration also plays a critical physiological role in optimizing your metabolism during active fat reduction phases of your clinical program. Drinking adequate water helps your liver process metabolized fat efficiently and often prevents false hunger signals from disrupting your progress. Most clinical specialists recommend consuming at least half your body weight in ounces of water daily for optimal metabolic health.
Fiber is another crucial dietary component that significantly enhances the overall effectiveness of medical weight management and non surgical weight loss. Consuming adequate dietary fiber slows down digestion and promotes a robust, highly functioning gut microbiome for better nutrient absorption. A flourishing gut microbiome has been clinically proven to support more efficient metabolic function and fat oxidation in most patients.
How to Start Your Non Surgical Weight Loss and Medical Weight Loss Journey Today
Beginning a medical weight management program requires careful planning and a comprehensive clinical evaluation from experienced obesity treatment professionals. How exactly do you transition from researching options to actually starting a proven clinical protocol for your health? Following a structured diagnostic pathway helps you build a solid foundation for your upcoming health transformation and long-term success.
How to Begin Your Clinical Protocol
1. Consult an Obesity Medicine Specialist
Schedule an initial consultation with a board-certified physician to discuss your complete medical history and weight loss goals. They will evaluate your metabolic health and determine which non surgical interventions match your specific biological needs and lifestyle.
2. Complete Metabolic Lab Testing
Run a comprehensive metabolic panel to identify any underlying hormonal imbalances or hidden nutritional deficiencies that may hinder progress. This objective data allows your physician to create an accurate baseline for tracking your future progress and health improvements.
3. Implement the Comprehensive Plan
Work with your healthcare team to implement your prescribed medication protocol and nutritional guidelines simultaneously for best results. You must remain consistent with your daily routines to maximize the effectiveness of these medical interventions and lifestyle changes.
The Role of Behavioral Therapy in Clinical Non Surgical Weight Loss
Physical treatments address the biological components of obesity, but psychological support is equally critical for achieving a healthy body composition. Cognitive Behavioral Therapy (CBT) helps patients identify and restructure negative thought patterns related to food consumption and emotional triggers. Working closely with a behavioral specialist allows you to dismantle deep-rooted emotional eating habits effectively and permanently.
Stress and inadequate sleep dramatically elevate cortisol levels, which actively promotes fat storage around your midsection and stalls your progress. A comprehensive behavioral plan includes targeted strategies for stress management and sleep hygiene optimization to support your metabolic health. By improving your daily recovery routines, you create a hormonal environment that supports your clinical weight loss treatments and goals.
Accountability coaching provides the ongoing external motivation required during challenging phases of your health transformation and non surgical weight loss. Regular check-ins with a professional keep you focused on your goals when your initial enthusiasm inevitably fades over time. This continuous support system dramatically increases the probability that you will maintain your results permanently and avoid weight regain.
Many patients discover that their social environments heavily influence their daily eating and physical activity patterns during their journey. A skilled behavioral coach helps you manage social gatherings and family dinners without compromising your progress or feeling isolated. You will learn specific communication strategies to set healthy boundaries with well-meaning friends and relatives regarding your choices.
- Cognitive Behavioral Therapy addresses the psychological aspects of emotional eating habits.
- Managing stress and sleep optimizes your cortisol levels for better fat reduction.
- Professional coaching provides necessary accountability to maintain your results permanently.
Tracking Progress and Metabolic Health During Non Surgical Weight Loss
The standard bathroom scale only tells a very small fraction of your overall non surgical weight loss transformation story. Measuring your body composition provides a much more accurate picture of your actual fat reduction progress and muscle preservation. Tools like DEXA scans reveal exactly how much dangerous visceral fat you have lost around your internal organs during treatment.
Metabolic health markers offer objective medical data that proves your internal systems are functioning much better than before starting. Your physician will likely monitor your fasting insulin, hemoglobin A1C, and comprehensive metabolic health markers regularly to ensure safety. Seeing these crucial numbers improve often provides incredible motivation to continue following your prescribed clinical protocol and lifestyle changes.
Non-scale victories frequently become the most rewarding aspect of a comprehensive non surgical weight loss program for many patients. Patients regularly report dramatic improvements in their daily energy levels, joint mobility, and overall sleep quality after starting treatment. These tangible lifestyle enhancements ultimately matter far more than reaching an arbitrary number on a digital scale in the morning.
Taking consistent progress photographs provides undeniable visual evidence of your changing physical shape and healthy body composition over time. When you see yourself in the mirror every single day, you often miss the gradual physical improvements occurring internally. Comparing monthly photographs allows you to recognize the profound changes happening to your overall body composition and physical appearance.
Conclusion: Achieving Lasting Non Surgical Weight Loss and Medical Weight Loss Results
Modern medicine has completely revolutionized how we approach and treat chronic metabolic conditions through non surgical weight loss in the United States. Non surgical weight loss provides a highly effective, scientifically validated pathway for reclaiming your overall physical health and vitality. Are you ready to take control of your metabolic health through proven medical science and expert clinical guidance?
Success requires a steadfast commitment to combining advanced medical therapies with sustainable, long-term lifestyle modifications for the best outcomes. By partnering with qualified healthcare professionals, you can finally achieve the healthy body composition you deserve and have always wanted. Take that critical first step today and explore the incredible medical weight loss options available for your personal health transformation.




